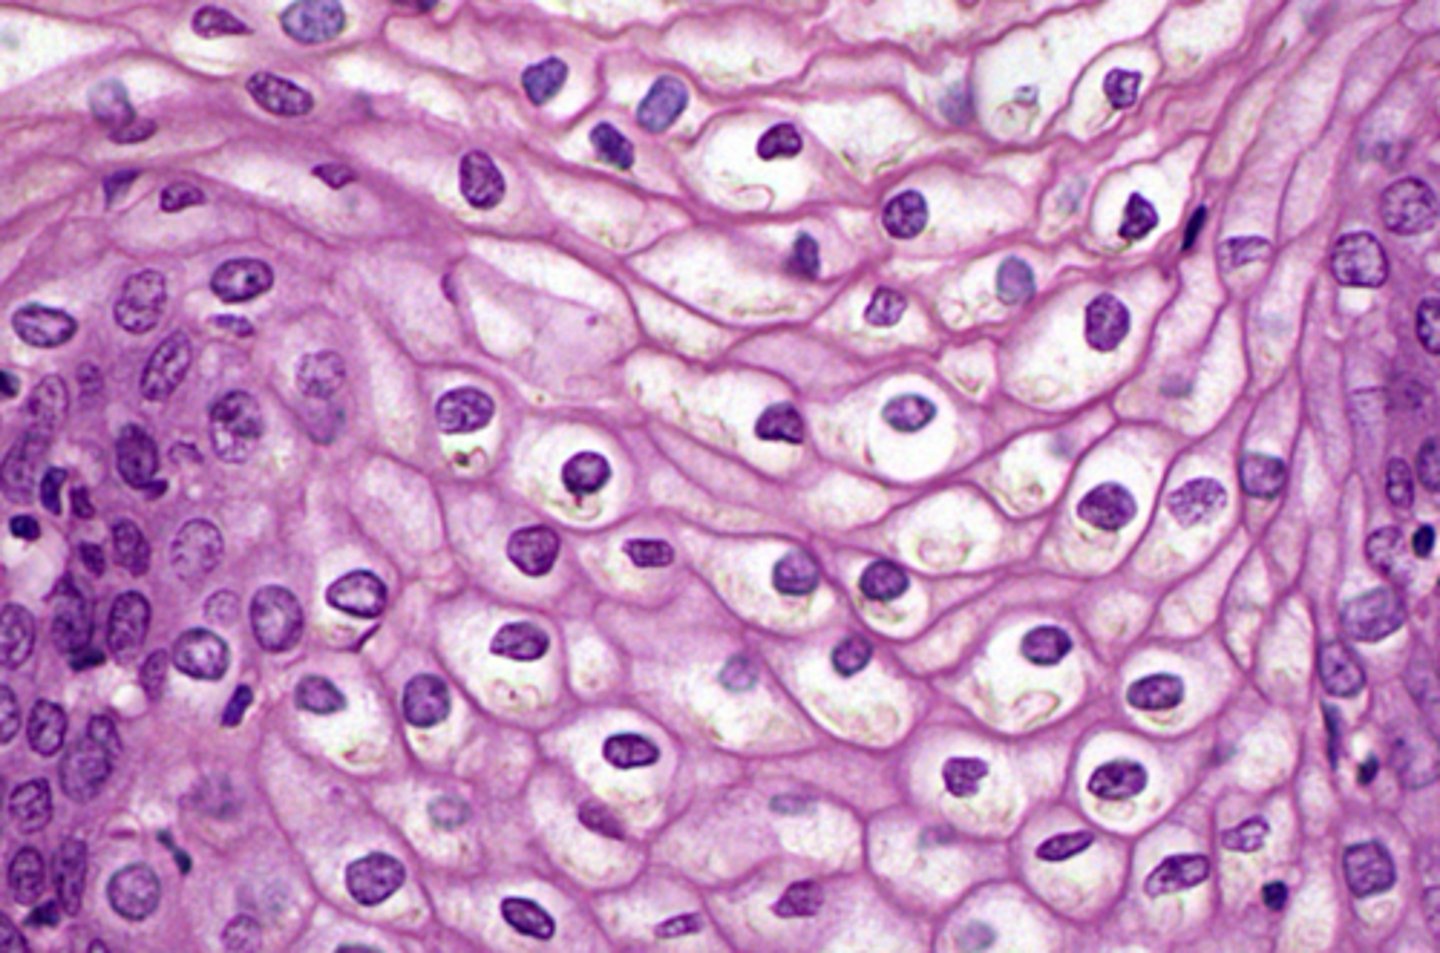
<p>most superficial layer of skin</p>

1/220
Looks like no tags are added yet.
Name | Mastery | Learn | Test | Matching | Spaced | Call with Kai |
|---|
No analytics yet
Send a link to your students to track their progress
Simple squamous epithelium
lines blood vessels

simple cuboidal epithelium
lines some glands

simple columnar epithelium
lines GI tract

stratified squamous epithelium
most superficial layer of skin
Pseudostratified ciliated columnar epithelium
throughout the respiratory tract

transitional epithelium
urinary bladder and ureters

Loose Connective Tissue
ex. adipose
few CT fibres, more ground substance

dense regular connective tissue
ex - elastic tissue
more CT fibres, less ground substance

dense irregular connective tissue

collagen fibres
most common
high tensile strength
looks like rope

reticular fibres
no alignment
interwoven network

elastic fibres
thin and branched
wavy/curly
able to stretch

Bone histology

elastic cartilage histology
more flexible

hyaline cartilage histology
most common
wear-resistant

fibrocartilage histology
tough and inflexible

Frontal bone
forehead and roof of orbits

Temporal bone
lateral and inferior skull

zygomatic process

external auditory (acoustic) meatus

mastoid process

sphenoid bone
'the keystone' - attaches with almost every other bone in the skull
looks like bat with wings

parietal bone
superior and lateral surfaces

occipital bone
posterior wall and skull base

foramen magnum
allows spinal cord to exit

occipital condyles
articulates with first neck bone

Coronal Suture
frontal and parietal

Sagittal Suture
between parietal

Lambdoid suture
occipital and parietal bones

Squamous suture
between temporal and parietal bones

maxillary
upper jaw

Nasal Bone
articulate with frontal
nose bridge

Zygomatic bone
cheekbones
temporal process articulates with zygomatic process of temporal bone

Mandible
lower jaw
3 parts - ramus, angle, and body

cervical vertebrae

thoracic vertebrae

lumbar vertebrae

Sacrum

Coccyx

Vertebral Body
anterior

Vertebral foramen
houses spinal cord
stacked vertebrae stack to form vertebral canal

Vertebral spinous process
extends posteriorly

vertebral transverse process
paired
extends laterally

Anterior arch on atlas
articulates with dens of C2
'no movement'

Articular surface for occipital condyles on atlas
surface for occipital condyle articulation
'yes movement'

dens of axis

intervertebral disc
shock absorber

Intervertebral foramina
lateral openings
passage of spinal nerves

head of rib

neck of rib

coastal tubercle

angle of rib

manubrium
articulates with rib 1

sternal body
articulates with ribs 2-7

xiphoid process

scaupula
coracoid process, acromion, and glenoid fossa
stabilizes head of humerus

clavicle
manubrium to scapula

coracoid process

spine of scapula

acromion

glenoid fossa

acromial end of clavicle

sternal end of clavicle

Humerus

head of humerus
articulates with glenoid fossa

anatomical neck of humerus

surgical neck of humerus
below tubercles

olecranon fossa
articulates with olecranon of ulna

medial epicondyle

lateral epicondyle

capitulum
think circle
articulates with the radius

trochlea
articulates with ulna medially

ulna
medially placed

radius
laterally placed

head of radius
proximal
disc shaped
articulates with capitulum and ulna

neck of radius

styloid process of radius
articulates with carpal bones
wide and flat

trochlear notch

head of ulna
distal end

styloid process of ulna

olecranon
proximal end of ulna
fits into olecranon fossa
trochlear notch = C shaped depression interlocking with trochlea

metacarpal bones
5 long bones

carpal bones
8 short bones

phalanges
14 long bones

iliac crest

anterior superior iliac spine (ASIS)

anterior inferior iliac spine (AIIS)

Posterior Superior Iliac Spine (PSIS)

posterior inferior iliac spine (PIIS)

greater sciatic notch
between PIIS and ischial spine
major nerves and vessels from pelvic cavity into posterior region of lower limb

lesser sciatic notch
between ischial spine and ischial tuberosity
structures from pelvic cavity to genital region

acetabulum
articulates with head of femur

obturator foramen
passage of nerves and blood vessels
anterior and inferior

symphasis pubis

ischial spine

ischial tuberosity

femur
thigh bone

head of femur
articulates with acetabulum
proximal end

neck of femur

medial condyle of femur
